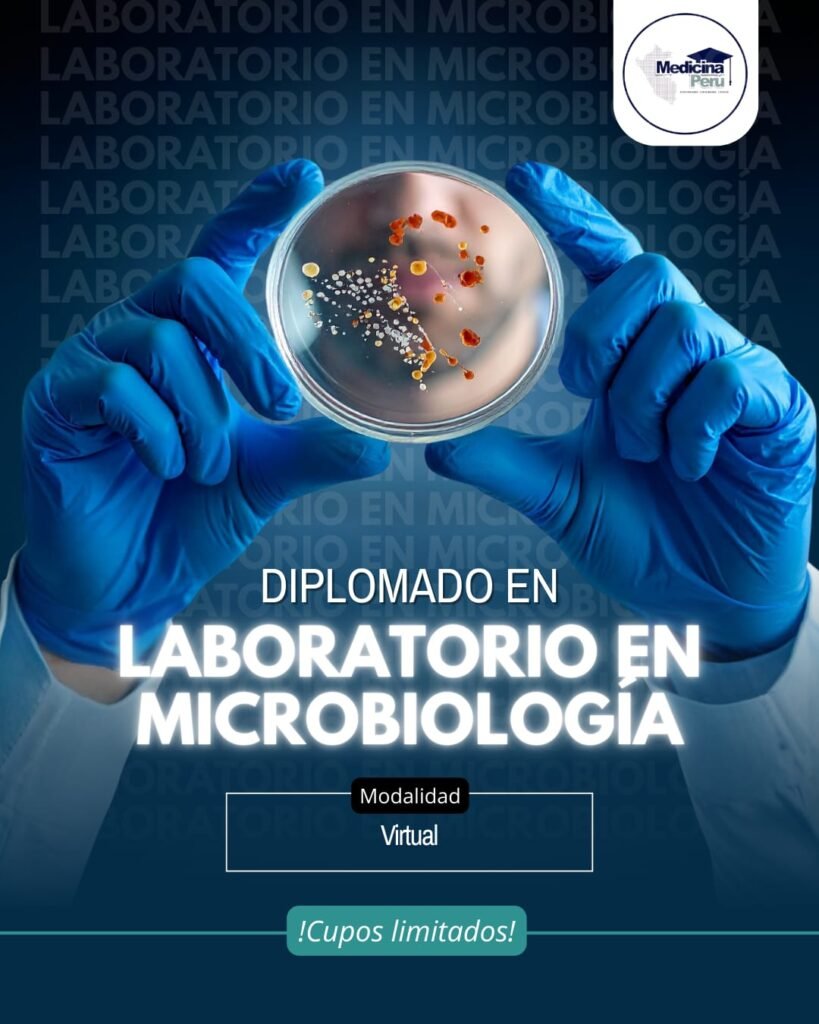

Diplomados
Programas actualizados con contenido práctico y enfocado en las necesidades reales del sector salud y profesional.

Diplomado en Cirugía Laparoscópica Ginecológica Avanzada

Diplomado en Ecografía en Ginecología

Diplomado en Ecografía en Oncología

Diplomado en Ecografía Renal y Vías Urinarias

Diplomado en Ecografía Cardiovascular Avanzada

Diplomado en Ecografía Músculo-Esquelética

Diplomado en Ecografía General

Diplomado en Ecografía Obstétrica Avanzada

Diplomado en Ecografía Veterinaria

Diplomado en Oftalmología General

Diplomado en Medicina Estética

Diplomado en Parasitología Clínica
Diplomado en Laboratorio en Microbiología

Diplomado en Emergencias Pediátricas

Diplomado en Cuidados Intensivos Neonatales

Diplomado en Farmacia Clínica y Atención Farmacéutica

Diplomado en Salud Pública con Mención en Salud Familiar y Comunitaria

Diplomado en Psicología Clínica

Diplomado en Cirugía Menor Ambulatoria

Diplomado en Centro Quirúrgico y Central de Esterilización
